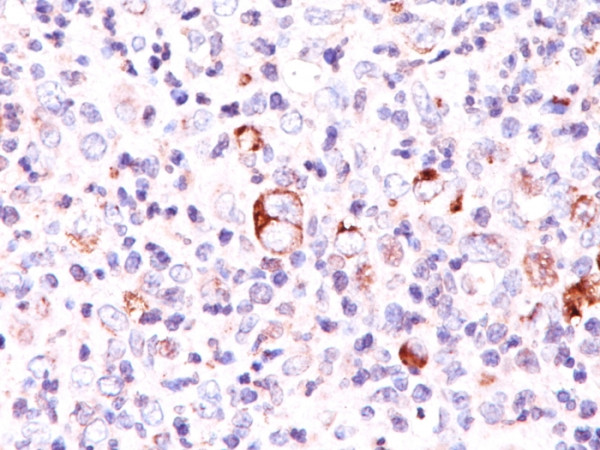
Anti-Bcl-X (Apoptosis Marker), clone SPM165

Cookie preferences
This website uses cookies, which are necessary for the technical operation of the website and are always set. Other cookies, which increase the comfort when using this website, are used for direct advertising or to facilitate interaction with other websites and social networks, are only set with your consent.
Configuration
Technically required
These cookies are necessary for the basic functions of the shop.
"Allow all cookies" cookie
"Decline all cookies" cookie
CSRF token
Cookie preferences
Currency change
Customer-specific caching
FACT-Finder tracking
Individual prices
Selected shop
Session
Comfort functions
These cookies are used to make the shopping experience even more appealing, for example for the recognition of the visitor.
Note
Show the facebook fanpage in the right blod sidebar
Statistics & Tracking
Affiliate program
Conversion and usertracking via Google Tag Manager
Track device being used
| Item number | Size | Datasheet | Manual | SDS | Delivery time | Quantity | Price |
|---|---|---|---|---|---|---|---|
| NEO-598-MSM2X-P1ABX | 100 µg | - | - |
Request delivery time estimate |
704.00€
|
If you have any questions, please use our Contact Form.
You can also order by e-mail: info@biomol.com
Larger quantity required? Request bulk
You can also order by e-mail: info@biomol.com
Larger quantity required? Request bulk
Formulation: Purified Ab WITHOUT BSA and Azide at 1.0mg/ml. Cellular Localization: Centrosome,... more
Product information "Anti-Bcl-X (Apoptosis Marker), clone SPM165"
Formulation: Purified Ab WITHOUT BSA and Azide at 1.0mg/ml. Cellular Localization: Centrosome, Cytoplasm, Cytoplasmic vesicle, Cytoskeleton, Cytosol, Microtubule organizing center, Mitochondrion inner membrane, Mitochondrion matrix, Mitochondrion outer membrane, Nucleus membrane, Secretory vesicle, Synaptic vesicle membrane. Positive Control: HL-60 or HeLa cells. Reed-Sternberg cells in Hodgkin's lymphoma., Jurkat, K562. Chromosome Location: 20q11.21. Protein Function: Potent inhibitor of cell death. Inhibits activation of caspases. Appears to regulate cell death by blocking the voltage-dependent anion channel (VDAC) by binding to it and preventing the release of the caspase activator, CYC1, from the mitochondrial membrane. Also acts as a regulator of G2 checkpoint and progression to cytokinesis during mitosis , Isoform Bcl-X(L) also regulates presynaptic plasticity, including neurotransmitter release and recovery, number of axonal mitochondria as well as size and number of synaptic vesicle clusters. During synaptic stimulation, increases ATP availability from mitochondria through regulation of mitochondrial membrane ATP synthase F(1)F(0) activity and regulates endocytic vesicle retrieval in hippocampal neurons through association with DMN1L and stimulation of its GTPase activity in synaptic vesicles. May attenuate inflammation impairing NLRP1-inflammasome activation, hence CASP1 activation and IL1B release (PubMed:17418785) , Isoform Bcl-X(S) promotes apoptosis [The Uniprot Consortium]
| Keywords: | Anti-BCL2L1, Anti-Bcl-2-like protein 1, Anti-Apoptosis regulator Bcl-X, 559 |
| Supplier: | NeoBiotechnologies |
| Supplier-Nr: | 598-MSM2XABX |
Properties
| Application: | FC, IF, IHC, WB |
| Antibody Type: | Monoclonal |
| Clone: | SPM165 |
| Conjugate: | No |
| Host: | Mouse |
| Species reactivity: | human, mouse, swine, rat |
| MW: | 27 kD |
| Format: | Purified |
Database Information
| KEGG ID : | K04570 | Matching products |
| UniProt ID : | Q07817 | Matching products |
| Gene ID : | GeneID 598 | Matching products |
Handling & Safety
| Storage: | -20°C |
| Shipping: | +4°C (International: +4°C) |
Caution
Our products are for laboratory research use only: Not for administration to humans!
Our products are for laboratory research use only: Not for administration to humans!
You will get a certificate here
Viewed